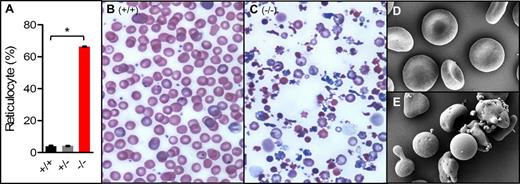
Figure 1.

Abstract
Dematin is an actin binding and bundling protein originally identified as a component of the erythrocyte membrane junctional complex. A widely expressed member of the villin-family of adaptor proteins, dematin regulates RhoA activity and cell shape in fibroblasts. Actin binding and bundling activity of dematin is regulated by phosphorylation of its headpiece domain by the cAMP-dependent protein kinase. Despite its extensive biochemical characterization, the physiological function of dematin in mature erythrocytes remains unknown. We used a conditional gene disruption strategy by generating a targeting construct that has the potential for full body gene knockout as well as tissue-specific deletion of dematin gene using the Cre-lox gene deletion system. Wild type, heterozygous, and homozygous progeny were obtained in a typical Mendelian ratio of 1:2:1. Dramatic splenomegaly in 7-week old full length dematin knockout (FLKO) mice was observed with the average spleen weight 10-fold higher than those of the wild type littermates. Flow cytometry showed a ~16-fold increase in reticulocytes (Fig.1A), which was also seen in the blood smear (Fig.1B,C). Severe hemolytic anemia is most likely the cause of relative pallor observed in FLKO mice at day 1 after birth. The adult FLKO mice continue to show relatively smaller body size as compared to wild type and heterozygous mice. These findings are consistent with severe anemia and compensatory erythropoiesis. FLKO mice exhibit typical signs of anisocytosis, microcytosis, macrocytosis, and polychromasia, which are indicative of tremendous variation in RBC cell size and the premature release of reticulocytes from the bone marrow. Moreover, additional RBC abnormalities, including poikilocytosis, acanthocytosis, fragmented RBC, and spherocytes, are consistent with severe hemolytic disease. By scanning EM, the FLKO erythrocytes showed dramatic variation in shape and size. The spherocytes, microcytic vesiculation, and the protruding structures are observed in FKLO mice, as well as extensive intravascular hemolysis (Fig. 1D,E). RBC half-life measurements in vivo by NHS-biotin labeling and flow cytometry showed mutant cells almost immediately cleared from the circulation in FLKO mice. A seven-week chase experiment showed that the half-life of RBCs was reduced from 22 days in wild type and heterozygous mice to less than 3 days in FLKO mice. The hematological phenotype of FLKO mice indicated reduced RBC count, hemoglobin, and hematocrit with increase in the RBC distribution width. Collectively, these findings indicate that the mechanical strength of RBC membrane strictly relies on the presence of full length dematin.
We employed membrane fractionation, in vitro protein domain mapping, transmission/scanning electron microscopy, and dynamic deformability measurements to investigate the underlying mechanisms of extreme membrane fragility in FLKO erythrocytes. We also examined the protein profile of RBC ghosts. Surprisingly, the major cytoskeletal proteins remained unchanged in the FLKO ghosts; however, a marked reduction of spectrin, adducin, and actin was observed. When normalized against band 3, these proteins were reduced by 60%, 90%, and 90%, respectively. Since these membrane proteins are essential for RBC stability, our findings suggest a specific role of dematin in recruiting or maintaining a stable association of essential cytoskeletal proteins in the plasma membrane. These results raise the possibility that dematin may directly interact with adducin, and together anchor the spectrin molecules to the plasma membrane. Our findings provide the first in vivo evidence that dematin is essential for the maintenance of erythrocyte shape and membrane mechanical properties by regulating the integrity of the spectrin-actin junctions.
No relevant conflicts of interest to declare.
Author notes
Asterisk with author names denotes non-ASH members.